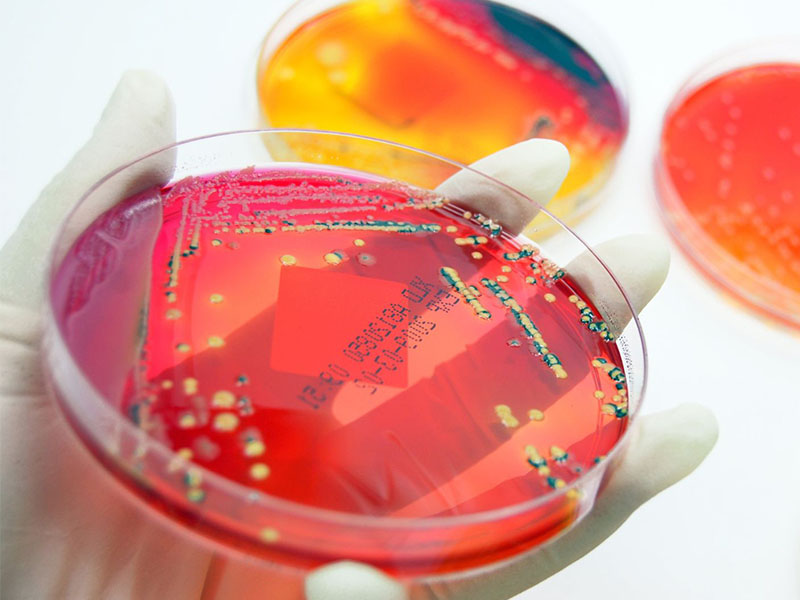

About Prime
Philippine-based Prime, comprised of Prime Certification & Inspection Asia Pacific Inc. and P Lab, is a reliable and trustworthy conformity assessment body that specializes in the fields of certification, testing, auditing, inspection, training, research and study.
We are the first local Halal Certification Body (HCB) accredited by the Philippine Department of Trade and Industry through the Philippine Accreditation Bureau. In addition, Prime is the only local HCB accredited by the National Commission on Muslim Filipinos, following the requirements of the Organization of Islamic Countries. We are, likewise, an accredited and approved HCB by the governing authorities of the United Arab Emirates, Kingdom of Saudi Arabia, State of Qatar, and other Gulf Cooperation Council countries.
The organization’s success is built upon our commitment to excellence, continuous innovation, and providing best-in-class solutions to our clients in the areas of quality, compliance, and growth.
With the backing of our UAE-based parent company, Prime Group, with a 600-man strong team, we have established a global footprint that has equipped us to scale our operations and offer a wide range of end-to-end solutions.
1st
Halal Certification Body Accredited by DTI’s PAB
USD XX
Value of Trade being Supported Every Year
300+
Certificates and Reports Issued
About Prime
Philippine-based Prime, comprised of Prime Certification & Inspection Asia Pacific Inc. and P Lab, is a reliable and trustworthy conformity assessment body that specializes in the fields of certification, testing, auditing, inspection, training, research and study.
We are the first local Halal Certification Body (HCB) accredited by the Philippine Department of Trade and Industry through the Philippine Accreditation Bureau. In addition, Prime is the only local HCB accredited by the National Commission on Muslim Filipinos, following the requirements of the Organization of Islamic Countries. We are, likewise, an accredited and approved HCB by the governing authorities of the United Arab Emirates, Kingdom of Saudi Arabia, State of Qatar, and other Gulf Cooperation Council countries.
The organization’s success is built upon our commitment to excellence, continuous innovation, and providing best-in-class solutions to our clients in the areas of quality, compliance, and growth.
With the backing of our UAE-based parent company, Prime Group, with a 600-man strong team, we have established a global footprint that has equipped us to scale our operations and offer a wide range of end-to-end solutions.
1st
Halal Certification Body Accredited by DTI’s PAB
USD 17.4M
Value of Trade being Supported Every Year
300+
Certificates and Reports Issued
Our
Brands


Our Services
A range of services are
tailored to meet your needs
Certification
Analytical Testing
Trainings
Business Solutions
Our Services
A range of services are
tailored to meet your needs
Certification
Analytical Testing
Trainings
Business Solutions
Our
Sectors
Animal
Farming
Chemical
Manufacturing
Cosmetics
Production
Equipment
Manufacturing
Food
Production
Food
Contact
Food Service & Hospitality
Ingredients
Production
Packaging Material
Manufacturing
Perishable Animal Products
Perishable Fruit & Vegetable Products
Plant
Farming
Product Distribution
Transport & Storage
Our
Sectors
Animal
Farming
Chemical Manufacturing
Cosmetics
Production
Equipment
Manufacturing
Food
Production
Food
Contact
Food Service & Hospitality
Ingredients
Production
Packaging Material
Manufacturing
Perishable Animal Products
Perishable Fruit & Vegetable Products
Plant
Farming
Product Distribution
Transport & Storage
Our
Accreditations
We are recognized and approved by the following authorities:
- Department of Trade and Industry through the Philippine
Accreditation Bureau (as first accredited local Halal Certification Body/HCB) - National Commission on Muslim Filipinos (as first and only accredited local HCB, following the requirements of Organization of Islamic Cooperation)
- UAE Ministry of Industry and Advanced Technology through the Emirates National Accreditation System
- Dubai Municipality through the Emirates International Accreditation Center
- Saudi Food and Drug Authority
Contact Us
Send us an inquiry or ask a question
Please use this form or reach out to us at:
info@primeasiapacific.com
+632 8404 1002

Corporate Office
- 3rd Floor, Unit R04
Allegro Center, Chino Roces Avenue Extension,
Makati City, Metro Manila,
Philippines
Tel +632 236 5999
Branches
- 3rd Floor, Dimacisil
Bldg. Sinuat Ave,
Cotabato City - Unit 27B Philexcel
Business Park, Clark
Freeport Zone,
Pampanga, Philippines
Social
Facebook
Instagram
LinkedIn
Inquiries
info@primeasiapacific.com
+632 8404 1002

Corporate Office
- 3rd Floor, Unit R04
Allegro Center, Chino Roces Avenue Extension,
Makati City, Metro Manila,
Philippines
Tel +632 236 5999
Branches
- 3rd Floor, Dimacisil
Bldg. Sinuat Ave,
Cotabato City - Unit 27B Philexcel
Business Park, Clark
Freeport Zone,
Pampanga, Philippines
Social
Facebook
Instagram
LinkedIn
Inquiries
info@primeasiapacific.com
+632 8404 1002
© 2023 Prime Group